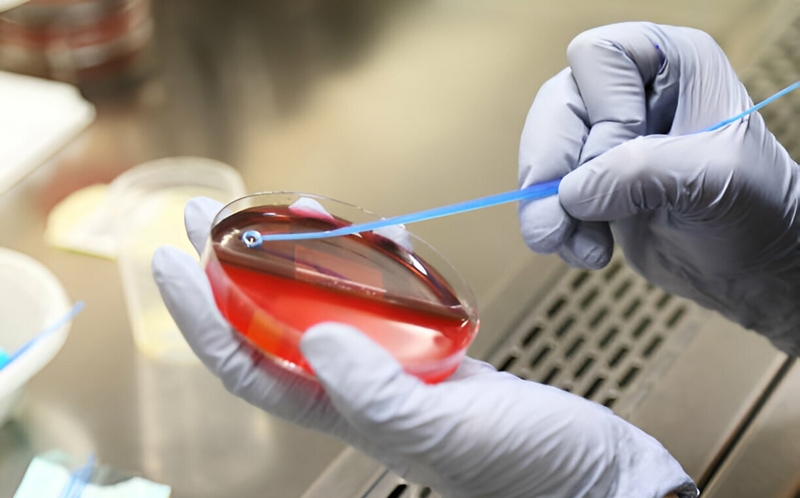
Thời gian có kết quả cấy máu phụ thuộc vào nhiều yếu tố khác nhau

Tốt nghiệp Đại học Y Dược TP. Hồ Chí Minh. Có nhiều năm trong lĩnh vực dược phẩm. Hiện đang là giảng viên cho Dược sĩ tại Nhà thuốc Long Châu.
Thanh Hương
28/01/2026
Mặc định
Lớn hơn
Cấy máu là xét nghiệm vi sinh quan trọng giúp phát hiện vi khuẩn hoặc nấm lưu hành trong máu, thường được chỉ định khi nghi ngờ nhiễm trùng nặng. Vậy cấy máu bao lâu có kết quả và vì sao chúng ta thường phải chờ đợi khá lâu?
Khi bệnh nhân có biểu hiện sốt cao kéo dài, rét run hoặc nghi ngờ nhiễm trùng nặng, bác sĩ thường chỉ định cấy máu. Không giống các xét nghiệm máu thông thường, cấy máu cần thời gian theo dõi vi sinh vật phát triển. Vậy cấy máu chờ bao lâu có kết quả và thời gian chờ này phụ thuộc vào những yếu tố nào?
Cấy máu là một xét nghiệm vi sinh quan trọng, được thực hiện bằng cách lấy mẫu máu của người bệnh đưa vào môi trường nuôi cấy chuyên biệt nhằm phát hiện sự hiện diện của vi khuẩn, nấm hoặc các vi sinh vật gây bệnh trong máu. Đây là phương pháp giúp xác định chính xác tác nhân gây nhiễm trùng, đồng thời hỗ trợ làm kháng sinh đồ để lựa chọn thuốc điều trị phù hợp, đặc biệt trong các trường hợp nhiễm trùng nặng hoặc đáp ứng điều trị kém.
Trong thực hành lâm sàng, cấy máu thường được chỉ định khi:

Cấy máu chờ bao lâu mới có kết quả là thắc mắc phổ biến của nhiều người bệnh khi được chỉ định xét nghiệm này. Hệ thống cấy máu tự động có thể phát hiện tín hiệu dương tính ban đầu thường trong vòng 24 - 72 giờ, tuy nhiên kết luận âm tính chỉ được đưa ra sau khi mẫu máu được theo dõi đầy đủ tối thiểu 5 ngày theo quy trình chuẩn. Sau khi có tín hiệu dương tính, việc định danh vi sinh vật và làm kháng sinh đồ thường cần thêm 1 - 2 ngày.
Khác với các xét nghiệm máu thông thường cho kết quả trong vài giờ, cấy máu không thể cho kết quả ngay vì bản chất của xét nghiệm là nuôi cấy vi sinh vật sống. Sau khi lấy máu, mẫu bệnh phẩm được đưa vào môi trường chuyên biệt và theo dõi liên tục để phát hiện dấu hiệu phát triển của vi khuẩn hoặc nấm. Quá trình này đòi hỏi thời gian và điều kiện kiểm soát nghiêm ngặt nhằm đảm bảo độ chính xác.
Cấy máu bao lâu có kết quả? Nhìn chung, thời gian trả kết quả cấy máu phụ thuộc trực tiếp vào quá trình nuôi cấy và phát hiện vi sinh vật trong mẫu máu, cũng như đặc điểm sinh học của tác nhân gây bệnh. Việc chờ đợi đủ thời gian là cần thiết để tránh bỏ sót vi khuẩn và giúp bác sĩ lựa chọn phác đồ điều trị phù hợp, an toàn cho người bệnh.
Quá trình cấy máu không chỉ cho ra một kết quả duy nhất mà được thực hiện và đánh giá theo nhiều giai đoạn liên tiếp. Mỗi giai đoạn có ý nghĩa riêng trong việc phát hiện, xác định tác nhân gây bệnh và định hướng điều trị.

Sau khi lấy máu, mẫu bệnh phẩm sẽ được đưa vào môi trường nuôi cấy và ủ trong điều kiện thích hợp để vi sinh vật phát triển. Ở giai đoạn này, hệ thống máy theo dõi sẽ phát hiện các tín hiệu tăng trưởng của vi khuẩn hoặc nấm trong mẫu máu. Thông thường, tín hiệu dương tính ban đầu có thể xuất hiện sau 24 - 72 giờ nếu lượng vi sinh vật đủ nhiều và phát triển nhanh. Kết quả dương tính sớm giúp bác sĩ sớm nghi ngờ tác nhân gây nhiễm trùng và cân nhắc điều chỉnh điều trị. Ngược lại, kết quả âm tính trong vài ngày đầu chỉ mang tính tạm thời và chưa đủ để loại trừ hoàn toàn nhiễm trùng máu.
Khi mẫu cấy máu cho tín hiệu dương tính, phòng xét nghiệm cần thêm thời gian để định danh chính xác chủng vi khuẩn hoặc nấm gây bệnh. Sau đó, xét nghiệm kháng sinh đồ sẽ được thực hiện nhằm đánh giá mức độ nhạy cảm hoặc kháng thuốc của vi sinh vật đối với các loại kháng sinh. Đây là bước quan trọng giúp bác sĩ lựa chọn thuốc điều trị phù hợp và hiệu quả nhất. Tổng thời gian cho giai đoạn này thường kéo dài từ 2 - 5 ngày, thậm chí lâu hơn với các tác nhân phát triển chậm hoặc cần kỹ thuật chuyên sâu.
Trong nhiều trường hợp, mẫu cấy máu không phát hiện vi khuẩn hoặc nấm trong những ngày đầu, nhưng phòng xét nghiệm vẫn cần theo dõi đủ số ngày quy định trước khi kết luận âm tính. Điều này nhằm tránh bỏ sót các vi sinh vật phát triển chậm hoặc có nồng độ thấp trong máu. Thông thường, kết luận âm tính chỉ được đưa ra sau khi mẫu được ủ và theo dõi đầy đủ theo quy trình chuẩn.
Kết quả cấy máu âm tính sau khi được ủ và theo dõi đầy đủ theo quy trình chuẩn (thường ≥ 5 ngày) có giá trị cao trong việc loại trừ nhiễm khuẩn huyết tại thời điểm xét nghiệm. Tuy nhiên, âm tính giả vẫn có thể xảy ra trong các trường hợp lấy mẫu không đúng kỹ thuật, đã dùng kháng sinh trước đó hoặc tải lượng vi sinh vật trong máu rất thấp.

Cấy máu bao lâu có kết quả phụ thuộc vào nhiều yếu tố như tác nhân gây bệnh, chất lượng mẫu xét nghiệm và điều kiện thực hiện. Cụ thể là:
Mỗi loại vi sinh vật có tốc độ phát triển khác nhau trong môi trường nuôi cấy. Vi khuẩn thông thường thường phát triển nhanh, có thể cho tín hiệu dương tính trong vòng vài ngày. Trong khi đó, nấm hoặc các vi khuẩn đặc biệt như các vi khuẩn phát triển chậm hoặc vi khuẩn kỵ khí thường cần thời gian nuôi cấy dài hơn. Chính sự khác biệt này khiến thời gian trả kết quả cấy máu ở mỗi trường hợp không hoàn toàn giống nhau.
Mẫu máu được lấy đúng kỹ thuật và đúng thời điểm, đặc biệt là khi người bệnh đang sốt cao hoặc rét run, sẽ làm tăng khả năng phát hiện vi sinh vật sớm hơn. Ngược lại, nếu người bệnh đã sử dụng kháng sinh trước khi lấy mẫu, số lượng vi khuẩn trong máu có thể giảm, khiến quá trình nuôi cấy kéo dài hoặc cho kết quả âm tính giả. Vì vậy, thời điểm lấy mẫu đóng vai trò rất quan trọng trong việc rút ngắn thời gian có kết quả.
Cấy máu bao lâu có kết quả phụ thuộc vào năng lực của phòng xét nghiệm. Các phòng xét nghiệm đạt chuẩn, được trang bị hệ thống cấy máu tự động và công nghệ hiện đại, thường có khả năng phát hiện vi sinh vật nhanh và chính xác hơn. Ngược lại, những cơ sở y tế nhỏ, trang thiết bị hạn chế hoặc quy trình thủ công có thể làm kéo dài thời gian xử lý mẫu.
Ở những người suy giảm miễn dịch, vi sinh vật có thể tồn tại với số lượng thấp hoặc gây nhiễm trùng không điển hình, khiến việc phát hiện và định danh trở nên phức tạp hơn. Ngoài ra, các trường hợp nhiễm trùng nặng, nhiễm đa tác nhân hoặc có nhiều bệnh nền cũng có thể làm kéo dài thời gian phân tích và trả kết quả cấy máu. Điều này đòi hỏi bác sĩ và phòng xét nghiệm phải theo dõi kỹ lưỡng để đảm bảo độ chính xác cao nhất.
Cấy máu là xét nghiệm quan trọng giúp xác định chính xác tác nhân gây nhiễm trùng huyết và nhiễm trùng máu, từ đó hỗ trợ bác sĩ lựa chọn kháng sinh phù hợp và kịp thời. Cấy máu bao lâu có kết quả phụ thuộc vào loại vi sinh vật, kỹ thuật xét nghiệm và điều kiện của phòng xét nghiệm, thường dao động từ vài ngày đến hơn một tuần. Hiểu rõ quy trình, thời gian trả kết quả và những lưu ý liên quan sẽ giúp người bệnh chủ động hơn trong việc chăm sóc sức khỏe và nâng cao hiệu quả điều trị.
Dược sĩ Đại họcNguyễn Vũ Kiều Ngân
Tốt nghiệp Đại học Y Dược TP. Hồ Chí Minh. Có nhiều năm trong lĩnh vực dược phẩm. Hiện đang là giảng viên cho Dược sĩ tại Nhà thuốc Long Châu.